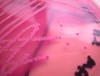
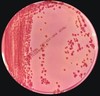
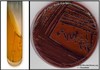
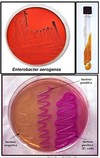
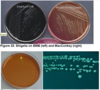
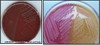
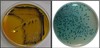

Gram (-) Rods Enterobacteriaceae (trans 1) Flashcards
(70 cards)
ENTEROBACTERIACEAE

Members of Enterobacteriaceae. Although Vibrio and Yersinia are found in the intestines, they are not member of the Enterobacteriaceae family.

ENTEROBACTERIACEAE - Characteristics
Large, heterogenous group of small gram (-) rods
Non-spore forming, facultative anaerobes (grow aerobically and anaerobically)
o Facultative: When grown in anaerobic environment it ferments carbohydrates for energy. But when given sufficient oxygen, will utilize the tricarboxylic acid cycle and the electron transport chain for energy production.
Found in soil, water, decaying matter, and large intestines of humans and animals; also in insects
Referred to as enteric bacilli or coliforms because of their normal habitat in humans
Members (from Zinnser)
o Escherichia
o Enterobacter
o Klebsiella
o Salmonella
o Shigella
o Serratia
o Citrobacter
o Proteus
ENTEROBACTERIACEAE - Characteristics
Most are opportunistic and can cause infection when they are displaced from their normal habitat
Responsible for the majority of nosocomial infections
All are non-encapsulated (except Klebsiella and Enterobacter; capsules are large and regular in Klebsiella species, less so in Enterobacter species, and uncommon in the other species)
All are motile with peritrichous flagella (except Klebsiella and Shigella)
Catalase positive and oxidase negative(except Plesiomonas)
All reduce nitrate to nitrite
All are glucose fermenters, often with gas production
Grow on peptone or meat extract media without the addition of sodium chloride or other supplements; grow well on MacConkey agar
Destroyed easily by heat and by low concentrations of germicides and disinfectants.
Can survive snow and ice for several months.
ENTEROBACTERIACEAE - Virulence Factors
Antigenic structures:
o Capsular Antigen (K): some are polysaccharides some are proteins; heat-labile
o Flagellar Antigen (H): used as a basis of antigenic typing (ex: Salmonella); denatured or removed by heat or alcohol; agglutinate with anti-H antibodies, mainly IgG
o Somatic Antigen (O): enhances the establishment of the organism in the host; heat-stable and alcohol-resistant. Antibodies to O antigens are predominantly IgM
COLONIZATION FACTORS
o Capsule: Antiphagocytic
o Fimbriae/Pili: For attachment to host cells (E.coli)
Determinants of Pathogenicity:
o Endotoxin (Lipid A)
A piece of the outer membrane lipopolysaccharide (LPS) of gram (-) bacteria
Very toxic and is released when the bacterial cell undergoes lysis (destruction)
Endotoxin is also shed in steady amounts from living bacteria
Contributes to high mortality (90%) in patients with gram (-) bacteremia due to endotoxic shock
Causes pooling of blood in the microcirculation w/c causes cellular hypoxia and metabolic failure due to inadequacy of blood in vital organs
o Enterotoxin
Causes transduction of fluid into the lumen of the small intestine w/ subsequent diarrhea
o Shiga Toxins and Shiga-like Toxins (Verotoxins)
Called “vero” because of its effects on vero tissue cells of African Green Monkeys
Shigella: produces a toxin that interferes with protein synthesis Verotoxin-producing E. coli (VTEC) aka EHEC: causes diarrhea and Hemolytic Uremic Syndrome (HUS).
*Hemolytic: causes microcytic hemolysis
*Uremic: renal failure; occurs after a bout of EHEC diarrhea
Some antibiotics may increase verotoxin production and precipitate HUS (ex Cotrimoxazole)
Effects of septic shock

BIOCHEMICAL TESTS
Traditionally, biochemical tests and growth on certain culture media are used to identify gram (-) bacteria
Some examples include; IMViC tests, growth characteristics on MacConkey, EMB, SSA, HEA.
- IMViC tests
- MacConkey agar
- Triple Sugar Iron agar (TSI)
- Eosin Methylene Blue agar (EMB)
- Salmonella-Shigella agar
- Hektoen Enteric agar (HEA)
BIOCHEMICAL TESTS - IMViC tests
Consists of four separate tests: Indole, Methyl red, Vogesproskauer, and Citrate utilization.
Indole Test: Identifies organisms that can digest tryptophan to indole
(+) result: Red ring at the upper layer indicates the presence of indole which is detected by the addition of Kovac’s reagent (ex: E. coli)
(-) result: No red ring (ex: Klebsiella)
Indole test. Left: negative result; Right: Positive result

BIOCHEMICAL TESTS - IMViC tests
**Methyl Red Test
- is a pH indicator that changes color depending on the pH of the environment. When used as a test, it detects glucose fermentation to acidic products.
(+) result: Red color (ex: E. coli)
(-) result: Yellow color (ex: Enterobacter, Klebsiella)
Methyl Red Test. Left: Positive result yields red color; Right: Negative result is yellow color.

BIOCHEMICAL TESTS - IMViC tests
**Voges-Proskauer Test
- Identifies organisms that digest glucose to acetylmethyl carbinol.
*Organisms that are Methyl red (+) will be VP(-) and vice versa.
(+) result: pink to red color (ex: Enterobacter, Klebsiella)
(-) result: yellow color (ex: E. coli)
Voges-Proskauer Test. Left: Positive result yields red color; Right: Negative result is yellow color

BIOCHEMICAL TESTS - IMViC tests
**Citrate utilization
- This is done in a Simmon Citrate agar (SCA). Tests organisms’ ability to use citrate as a source of carbon. It contains bromthymol blue which changes color from green to blue in an alkaline environment.
(+) result: SCA turns blue (ex: Enterobacter, Klebsiella, Citrobacter)
(-) result: SCA remains green (ex: E. coli)
Citrate utilization. Left: Negative result remains green; Right: Positive result turns blue

BIOCHEMICAL TESTS - IMViC tests
IMViC results for some bacteria

BIOCHEMICAL TESTS - MacConkey agar
Is a selective and a differential media which selects for gram negative and differentiates between lactose (LF) and non-lactose (NLF) fermenters.
Contains bile salts and crystal violet to inhibit gram positive organisms, and contains phenol red to detect lactose fermentation
Lactose fermenters grow as pink colonies in Mac, while non-lactose fermenters are colorless.
E. coli in MacConkey agar which produces pink colonies

BIOCHEMICAL TESTS - Triple Sugar Iron agar (TSI)
One of the most commonly used media to differentiate between enteric bacteria.
Contains sucrose, lactose and glucose in 10:10:1 ratio with phenol red as an indicator
Detects an organisms ability to ferment glucose, lactose, produce gas and to produce Hydrogen sulfide (H2S)
All enteric bacteria that can ferment lactose can ferment glucose, hence they will turn the butt and the slant yellow (A/A)
Not all enteric bacteria that can ferment glucose are able to ferment lactose hence they can only turn the butt yellow. (K/A)
Gas production is seen as bubbles or cracks in the agar
This also has ferrous sulfate and if the bacteria forms H2S, this chemical will react with the iron to form ferrous sulfide seen as a black precipitate in the butt
TSI results for some bacteria. From left => right: Uninoculated control, Pseudomonas aeruginosa, Shigella sonnei, Salmonella typhi, Escherichia coli, Proteus mirabilis

TSI results for some bacteria.

BIOCHEMICAL TESTS - Eosin Methylene Blue agar (EMB)
Is both a selective and a differential media which contains eosin and methylene blue to inhibit G (+) organisms and lactose to differentiate LF from NLF
LF yields colored colonies while NLF has colorless colonies.
Only E. coli can produce the characteristic greenish metallic sheen in EMB
To differentiate Klebsiella and Enterobacter (since they have the same results in IMViC and TSI
E. coli in EMBA which produces green metallic sheen.

BIOCHEMICAL TESTS - Salmonella-Shigella agar
Specific for salmonella and shigella (suppresses the growth of other enteric and gram (+) organisms
Differentiates between the two by H2S production, Salmonella grows with black centers while Shigella has colorless colonies.
LEFT: Shigella on SSA, note the transparent colonies produced; RIGHT: Salmonella on SSA, note the colorless colonies with black center.

BIOCHEMICAL TESTS - Hektoen Enteric agar (HEA)
Also used to differentiate between Salmonella and shigella.
Shigella has blue-green colonies on HEA. Salmonella has black colonies on HEA.
LEFT: Shigella on HEA, note the blue-green colonies produced; RIGHT: Salmonella on HEA, note the transparent colonies with black centers.

ESCHERICHIA COLI

Characteristics
Facultative inhabitant of the large intestine
Part of the normal flora but can be pathogenic both within and outside of the GI tract (but more pathogenic when outside of its normal habitat)
Responsible for virtually all the clinically significant infections caused by the genus
UTI is the most common extra-GIT nosocomial infection caused by E. coli
Glucose and lactose fermenter
Produces both acid and gas during fermentation of carbohydrates
Reduces Nitrates to Nitrites to produce energy
Lacks cytochrome oxidase (oxidase negative)
May be beta-hemolytic on BAP
ESCHERICHIA COLI - Virulence Factors
Antigenic Structures:
o Serologic Typing is based on O Antigen, H Antigen and when applicable, the K Antigen.
o Antigenic profile is useful for epidemiologic studies:
O157:H7 produces Shiga-like Toxin causing hemorrhagic colitis and HUS
O78:H11 strains are enterotoxigenic
Determinants of Pathogenicity:
o Polysialic Acid Capsule (K1 Ag)
Enables the organism to resist killing by neutrophils
Aids in survival of organisms in the blood & CSF
Strains possessing this are more likely to cause neonatal sepsis
o S Fimbriae
Predilection for binding to vascular endothelium and ventricles of the brain.
o Other fimbriae
Binding to other host tissues
o Verotoxin (Shiga-like toxin)
VTEC is associated with diarrhea, hemorrhagic colitis and HUS
o Enterotoxins: Target organ is the small intestine
Heat Labile enterotoxin (LT) : Stimulates adenyl cyclase in the mucosa which increases permeability, resulting in the loss of fluids and electrolytes.
Heat Stable Enterotoxin (ST) : activates guanylate cyclase in the mucosa inhibiting Na and Cl reabsorption
ESCHERICHIA COLI - Clinical Manifestations
Intestinal Disease Transmission of intestinal disease is commonly by the fecal–oral route, with contaminated food and water serving as vehicles At least five types of intestinal infections that differ in pathogenic mechanisms have been identified. All are basically the same organism, differing only by the acquisition of specific pathogenic traits. o EnteroToxigenic (ETEC): Traveler’s diarrhea o EnteroPathogenic (EPEC): Infantile (inPantile)diarrhea o EnteroHemorrhagic(EHEC): HUS o Enteroinvasive (EIEC): Dysentery-like syndrome o Enteroaggregative (EAEC): Watery diarrhea
ESCHERICHIA COLI - ENTEROTOXIGENIC E. COLI (ETEC)
Common cause of traveler’s diarrhea.
Transmission: fecal–oral (contaminated food or water) or by person-to-person contact
ETEC colonizes the small intestine (pili facilitate the binding of the organism to the intestinal mucosa)
Enterotoxins cause prolonged hypersecretion of chloride, ions and water by the intestinal mucosal cells, while inhibiting the reabsorption of sodium. The gut becomes full of fluid, resulting in significant watery diarrhea that continues over a period of several days.
o Heat-stable toxin (ST): Causes an elevation in cellular (cGMP) levels by activating guanylate cyclase in the mucosa, inhibiting Na and Cl reabsorption
o Heat-labile toxin (LT): causes elevated (cAMP) by stimulating adenyl cyclase in the mucosa which increases permeability, resulting in the loss of fluids and electrolytes. LT is closely related in structure and function to cholera toxin.
ESCHERICHIA COLI - ENTEROTOXIGENIC E. COLI (ETEC)

Process of pathogenicity of Enterotoxigenic E.coli.
ESCHERICHIA COLI - ENTEROPATHOGENIC E. COLI (EPEC)
- Cause of diarrhea in infants, especially in locations with poor sanitation.
- The newborn becomes infected perinatally
- There is destruction of the microvilli in the small intestine.
- EPEC is not invasive; does not cause bloody diarrhea
- Toxins are not elaborated by EPEC strains.
- Watery diarrhea results, which, on rare occasions, may become chronic
ESCHERICHIA COLI - ENTEROPATHOGENIC E. COLI (EPEC)
It binds to cells in the large intestine and produces attaching and effacing lesions
Produces exotoxins (Shiga-like toxins 1 or 2), resulting in a severe copious, bloody diarrhea called as hemorrhagic colitis
Serotype 0157:H7 is associated w/ outbreaks of hemolytic uremic syndrome (HUS) characterized by fever, acute renal failure, microangiopathic hemolytic anemia, and thrombocytopenia in children ages 5 to 10 years
Primary reservoir: cattles
Possibility of infection can be decreased by thoroughly cooking ground beef and pasteurizing milk
Raw hamburgers are a culprit in the US
Note: HEMOLYTIC-UREMIC SYNDROME, abbreviated HUS, is a disease characterized by hemolytic anemia (anemia caused by destruction of red blood cells), acute kidney failure (uremia), and a low platelet count (thrombocytopenia). It predominantly, but not exclusively, affects children. Most cases are preceded by an episode of infectious, sometimes bloody, diarrhea acquired as a foodborne illness or from a contaminated water supply and caused by E. coli O157:H7. Certain antibiotic may stimulate further verotoxin production and thereby increase the risk of HUS. However there is also tentative evidence that some antibiotics like quinolones may decrease the risk of hemolytic uremic syndrome.